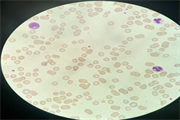

新闻动态
联系我们
陕西依科生物技术服务有限公司陕西依科生物技术服务有限公司主要展示{新疆抗体},{新疆单克隆抗体},{新疆多克隆抗体}等方面的相关信息以及资讯发布,欢迎您关注我站!
一,血涂片制作
取新鲜血液(若用抗凝管收集的血液,放置最好不要超过24h,否则血液中的白细胞的数量以及种类会明显减少),选用新疆粘附载玻片,用移液枪吸取10ul的血液,滴加在玻片的一侧(一般都是磨砂这边),再取一片干净的载玻片(也可选用盖玻片,依据个人手的力道习惯选择)的,以30°-40°角,用其窄面靠近血液,会发现血液会沿着接触边缘向两边晕开,当两边都要到达边缘时,轻轻的稳健且匀速的向另一侧涂片,至距离另一侧2cm左右的距离,快速果断的拿走载玻片,可见图片首尾分明,厚薄均匀。一般情况下,涂抹速度力道适中的话,取走玻片时载玻片上的血几乎无残留,且涂抹出的血涂片无明显细胞破碎,变形,在显微镜下可观察到其细胞是单个紧密的排列,整体比较均匀。将涂好的血涂片自然晾干,放入切片盒内于4℃冰箱保存,要做时拿出可直接染色。切记涂片手法很重要,不可涂的过薄,白细胞数量会很少或者都残留在了尾端,也不可涂得过厚,细胞区分不清晰,部分区域血膜稍厚没关系,只要大部分视野都挺好的就行。
二,精子涂片制作
取新鲜精液,选用干净的防脱玻片(载玻片),用组化笔画一个直径2cm左右的椭圆,用移液枪吸取100ul的精液置于圈内,用移液枪均匀涂满整个圈,放在摊片板内自然风干后入95%的乙醇固定15min,取出玻片自然晾干后常温寄送实验室。若没有条件自己做涂片,将精液的细胞悬液1200r/min,4℃离心5min后弃上清,留沉淀加入2ml的95%的酒精固定15min,常温寄送实验室。(如果没有离心机,请直接用每1ml的精子悬液,加入5ml的无水乙醇固定,常温寄送实验室)。
三,其他细胞悬液的涂片/滴片制备
取细胞悬液,2800r离心5min,弃上清液,加入多聚甲醛固定(其他染色)或甲醇(瑞士-吉姆萨)混匀,常温固定30min以上即可。取固定好的细胞悬液,2800r离心5min,弃上清液,根据底部沉淀的细胞量加入适量PBS缓冲液进行稀释:一般肉眼看不见细胞沉淀时,用3000r/min,25℃离心10min,依然无沉淀时,直接留取底部约0.2ml的液体,混匀后用移液枪吸取200ul,涂于提前用组化笔画好的小圆圈中(直径约3cm的圆);若细胞沉淀量很少,绿豆大小时,弃上清,留取底部沉淀,加入0.5mlPBS,用移液枪吹打混匀后,吸取200ul,涂于提前用组化笔画好的小圆圈中(直径约3cm的圆);若细胞沉淀量很多,黄豆大小或更大时,弃上清,留取底部沉淀,加入2mlPBS,用移液枪吹打混匀后,吸取150ul,涂于提前用组化笔画好的大圆圈中(最大长边约5cm,最大短边约2cm的椭圆),在显微镜下观察细胞量的多少,若还是过厚,再用PBS对倍稀释该细胞悬液,直至在显微镜下观察到细胞量涂布均匀。用枪将细胞悬液铺满整个圆圈,涂片放置自然晾干。
四,细胞悬液琼脂包埋
取细胞悬液,2800r离心5min,弃上清液,加入多聚甲醛固定或甲醇混匀,常温固定30min以上即可。取固定好的细胞悬液,2800r离心5min,弃上清液,滴一滴品红标记细胞,溶解2%的琼脂糖,取热的琼脂1-2ml加入EP管,自然冷却即可。
{陕西依科生物技术服务有限公司}口碑怎么样?{新疆单克隆抗体}哪里好?{新疆多克隆抗体}找哪家?陕西依科生物技术服务有限公司专业从事{生物科研试剂的研发、销售及相关技术服务}